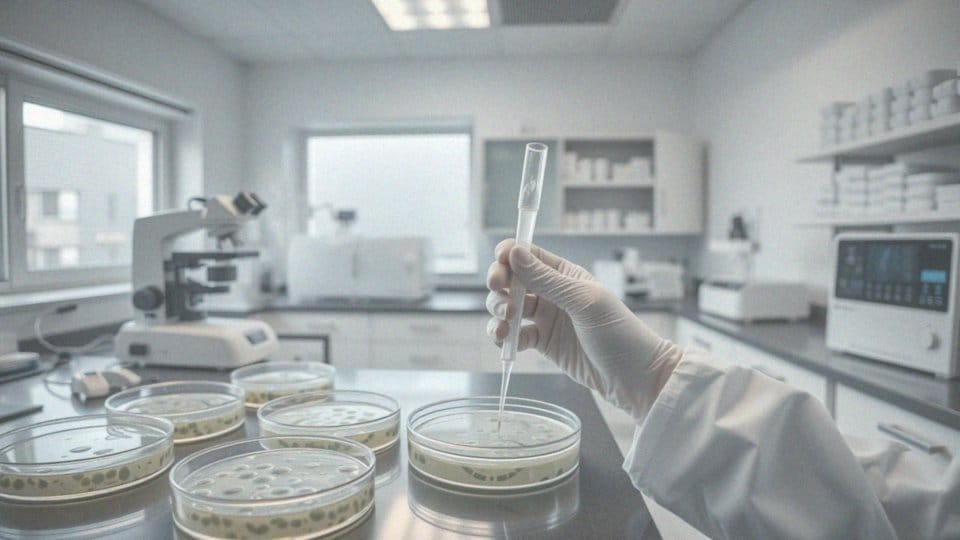

Spis treści
Co to jest Enterobacter cloacae?
Enterobacter cloacae to Gram-ujemna bakteria należąca do rodziny Enterobacteriaceae. Można ją znaleźć w różnych środowiskach, a także jako część mikroflory ludzkiego jelita. Choć zazwyczaj nie prowadzi do infekcji pierwotnych, u osób z osłabionym systemem odpornościowym staje się potencjalnie niebezpiecznym patogenem. W kontekście pacjentów z immunosupresją, może wywoływać poważne infekcje, zwłaszcza w szpitalach, gdzie ryzyko zakażeń jest znacząco zwiększone.
Ta bakteria ma zdolność do kolonizacji organizmu, co może prowadzić do różnorodnych zakażeń, w tym:
- w układzie moczowym,
- w układzie oddechowym,
- w ranach chirurgicznych,
- w krwiobiegu.
Obecność Enterobacter cloacae w moczu może wskazywać na ryzyko bakteriomoczu, co wymaga dalszej diagnostyki i ewentualnego leczenia.
Jakie zakażenia wywołuje Enterobacter cloacae?
Enterobacter cloacae to bakteria odpowiedzialna za różne zakażenia, szczególnie w środowisku szpitalnym. Może powodować infekcje:
- układu moczowego,
- bakteriemię, często bez widocznych symptomów,
- sepsę,
- infekcje płuc,
- zakażenia ran pooperacyjnych,
- zakażenia krwi.
Stanowi poważne zagrożenie, zwłaszcza dla osób z osłabionym układem odpornościowym, będąc istotnym czynnikiem ryzyka infekcji szpitalnych. W statystykach można zaobserwować rosnącą liczbę tego rodzaju zakażeń w placówkach medycznych, co jest efektem zarówno osłabienia pacjentów, jak i warunków panujących w szpitalach, które sprzyjają rozprzestrzenieniu bakterii. Takie infekcje mogą prowadzić do poważnych powikłań, co wykazuje znaczenie monitorowania sytuacji oraz szybkiej reakcji na pojawiające się zagrożenia.
Jakie są objawy zakażeń spowodowanych Enterobacter cloacae?
Objawy zakażeń wywołanych przez Enterobacter cloacae mogą się znacznie różnić w zależności od lokalizacji infekcji. Na przykład, gdy mamy do czynienia z zakażeniem układu moczowego, pacjenci często doświadczają:
- intensywnego parcia na pęcherz,
- pieczenia oraz bólu podczas oddawania moczu,
- dyskomfortu w dolnej części brzucha.
W bardziej zaawansowanych sytuacjach mogą pojawić się jeszcze:
- gorączka,
- symptomy odmiedniczkowego zapalenia nerek.
Gdy infekcja dotknie innych części ciała, zwykle manifestuje się ona:
- gorączką,
- dreszczami,
- różnorodnym bólem,
- zaczerwienieniem oraz obrzękiem w miejscu infekcji.
Dodatkowo, ogólne osłabienie i uczucie zmęczenia mogą sugerować, że doszło do rozwinięcia się infekcji w organizmie. Warto zwracać uwagę na te sygnały, gdyż mogą one informować o potencjalnie poważnych problemach zdrowotnych. Dlatego wczesne rozpoznanie jest tak istotne — ma kluczowe znaczenie dla efektywnego leczenia i może pomóc w uniknięciu powikłań.
Jak często występują zakażenia szpitalne wywołane Enterobacter cloacae?
Zakażenia szpitalne wywołane przez Enterobacter cloacae stanowią poważny problem zdrowotny, który wymaga naszej uwagi. Częstość ich występowania jest zróżnicowana w zależności od danej placówki oraz grupy pacjentów. Ta bakteria odpowiada za 5-10% wszystkich infekcji szpitalnych, zwłaszcza w przypadku osób o obniżonej odporności, na przykład tych, którzy przeszli operacje lub mieli zakładane cewniki.
Jednakże warto zauważyć, że dostępne dane statystyczne na ten temat są dość ograniczone. Leczenie zakażeń oraz warunki panujące w szpitalach znacząco wpływają na rozprzestrzenianie się tego patogenu. Dodatkowo, narastający problem oporności na antybiotyki staje się coraz bardziej alarmujący, co wprowadza dodatkowe trudności w terapii.
Dlatego niezwykle istotne jest:
- systematyczne monitorowanie zakażeń,
- wdrażanie skutecznych strategii prewencyjnych.
Dzięki temu możliwe jest ograniczenie negatywnego wpływu Enterobacter cloacae na zdrowie pacjentów w placówkach medycznych.
Jak Enterobacter cloacae wpływa na układ moczowy?

Enterobacter cloacae odgrywa znaczącą rolę w problematyce związanej z układem moczowym. Może powodować różnorodne infekcje, które niosą ze sobą poważne konsekwencje dla zdrowia. Najczęściej obserwowanymi schorzeniami są zakażenia, takie jak:
- zapalenie pęcherza moczowego,
- zapalenie gruczołu krokowego,
- odmiedniczkowe zapalenie nerek.
Pacjenci często skarżą się na pieczenie, intensywne parcie na mocz oraz dyskomfort w dolnej części brzucha. U mężczyzn ta bakteria dodatkowo może prowadzić do zapalenia gruczołu krokowego, objawiającego się bólem i nieprzyjemnymi doznaniami w obrębie miednicy. W odpowiednio ciężkich przypadkach wystąpienie odmiedniczkowego zapalenia nerek może zagrażać prawidłowemu funkcjonowaniu całego układu moczowego. Takie infekcje wiążą się z ryzykiem groźnych powikłań, w tym niewydolności nerek, zwłaszcza jeśli nie zostaną wdrożone właściwe leczenie. Warto także zwrócić uwagę, że Enterobacter cloacae może uszkadzać nabłonek dróg moczowych, co sprzyja rozwojowi stanów zapalnych oraz zwiększa prawdopodobieństwo nawrotów zakażeń. W przypadku stwierdzenia obecności tej bakterii w badaniach moczu, często można podejrzewać bakteriemię. Z tego względu właściwa diagnostyka oraz terapia stają się kluczowe i powinny być traktowane z najwyższym priorytetem. Odpowiednie leczenie jest istotne, aby zapobiec poważnym powikłaniom i chronić pacjentów przed ciężkimi konsekwencjami zdrowotnymi.
Jakie czynniki przyczyniają się do rozwoju bakteriomoczu?
Obecność bakterii w moczu, znana jako bakteriomocz, jest wynikiem działania wielu różnorodnych czynników. Do najważniejszych z nich należą:
- cewnikowanie pęcherza moczowego, które ułatwia patogenom dotarcie do dróg moczowych,
- trudności w odpływie moczu,
- kamienie nerkowe,
- ciąża, które wpływają na funkcjonowanie układu moczowego.
Osoby starsze oraz diabeticy często cierpią na osłabioną odporność, co podnosi prawdopodobieństwo wystąpienia zakażeń w obrębie układu moczowego. Warto także zwrócić uwagę na kwestie związane z higieną; jej zaniedbanie może sprzyjać rozwojowi bakterii. Niekontrolowane stosowanie antybiotyków prowadzi do powstawania opornych szczepów, takich jak Enterobacter cloacae, co jeszcze bardziej zwiększa ryzyko bakteriomoczu. Wszystkie te czynniki mogą prowadzić do wystąpienia objawów klinicznych lub też bakteriomoczu bezobjawowego. Dlatego, odpowiednia diagnoza oraz bieżąca kontrola stanu pacjenta są niezbędne, by ograniczyć ryzyko zakażeń i ich ewentualnych powikłań.
Jakie są metody zapobiegania zakażeniom układu moczowego wywołanym przez Enterobacter cloacae?
Zapobieganie zakażeniom układu moczowego, które mogą być spowodowane przez Enterobacter cloacae, ma kluczowe znaczenie, zwłaszcza w placówkach medycznych. Istnieje wiele sposobów, które mogą znacznie zmniejszyć prawdopodobieństwo wystąpienia takich infekcji. Przede wszystkim, niezwykle ważne jest przestrzeganie zasad higieny osobistej.
- regularne mycie rąk przed i po odwiedzeniu toalety,
- starannie unikane cewnikowanie pęcherza moczowego,
- odpowiednie nawodnienie organizmu,
- regularne opróżnianie pęcherza,
- korzystanie z probiotyków.
Dodatkowo, w środowisku szpitalnym kluczowe jest wprowadzenie dodatkowych procedur ostrożności, takich jak precyzyjne zasady dotyczące wprowadzania cewników oraz uważne monitorowanie stanu pacjentów. Dzięki skutecznym środkom prewencyjnym, możliwe jest znaczące ograniczenie ryzyka zakażeń szpitalnych, wywoływanych przez Enterobacter cloacae.
W jaki sposób diagnozuje się obecność Enterobacter cloacae?
Diagnostyka obecności Enterobacter cloacae opiera się na szczegółowych badaniach mikrobiologicznych. Kluczowym narzędziem w tej procedurze jest posiew moczu, który umożliwia oszacowanie liczby bakterii w jednostce objętości, wykazywanej jako CFU/ml (jednostki formujące kolonie na mililitr). Dzięki temu lekarze mogą ocenić, jak zaawansowane jest zakażenie oraz uzyskać cenną wiedzę o patogenach występujących w organizmie.
W przypadku podejrzenia infekcji układu moczowego warto także wykonać antybiogram, który określa, na jakie antybiotyki Enterobacter cloacae wykazuje wrażliwość. Informacja ta jest kluczowa dla skutecznego postępowania terapeutycznego.
Oprócz posiewu moczu, diagnostyka może obejmować badania takie jak:
- oznaczenie poziomu białka C-reaktywnego (CRP),
- analiza liczby leukocytów.
Ich podwyższone wartości mogą wskazywać na stan zapalny, co potwierdza obecność infekcji. Ważnym elementem w kontekście bakteriomoczu jest również przeprowadzenie dokładnego wywiadu medycznego, który pomaga zidentyfikować potencjalne źródła infekcji oraz czynniki ryzyka. W sytuacjach, gdy zachodzi taka potrzeba, diagnostyka może obejmować także dodatkowe badania obrazowe, które są niezbędne do oceny stanu układu moczowego oraz wykluczenia innych schorzeń.
Jakie są trudności w leczeniu zakażeń Enterobacter cloacae?
Leczenie infekcji spowodowanych przez Enterobacter cloacae to nie lada wyzwanie. Ta bakteria charakteryzuje się opornością na wiele dostępnych antybiotyków, w tym na beta-laktamy. Często wynika to z działania enzymów, takich jak beta-laktamazy AmpC, które osłabiają efektywność leków.
W codziennej praktyce medycznej niezwykle istotne jest przeprowadzenie antybiogramu, który pozwala na zidentyfikowanie najbardziej skutecznych medykamentów w danym przypadku. Jednakże w terapii mogą wystąpić trudności spowodowane naturalną selekcją szczepów odpornych na leczenie. Dodatkowo, pacjenci z osłabionym systemem odpornościowym, którzy często zmagają się z tymi infekcjami, wymagają bardziej skomplikowanego podejścia terapeutycznego.
Efekty leczenia mogą być także ograniczone przez konieczność stosowania silnych antybiotyków, które niosą ze sobą ryzyko poważnych skutków ubocznych. Coraz częściej zwraca się uwagę na możliwość:
- łączenia różnych antybiotyków,
- wprowadzenia do terapii nowych substancji czynnych, jak karbapenemy,
- które mogą być bardziej skuteczne w walce z opornymi zakażeniami.
Finalny wybór metody leczenia opiera się na wynikach antybiogramu oraz na klinicznej sytuacji pacjenta. To skomplikowany proces, który wymaga starannego monitorowania i dostosowywania terapii, aby skutecznie pokonywać zakażenia wywołane przez Enterobacter cloacae.
Jakie są możliwości antybiotykoterapii w przypadku zakażeń Enterobacter cloacae?
Leczenie zakażeń wywołanych przez Enterobacter cloacae jest zróżnicowane i w dużej mierze zależy od specyficznych reakcji poszczególnych szczepów na antybiotyki. Antybiogram odgrywa tu kluczową rolę, ponieważ pozwala na ustalenie, które leki będą najskuteczniejsze.
W praktyce medycznej najczęściej sięga się po:
- karbapenemy,
- fluorochinolony,
- aminoglikozydy,
- cefalozporyny IV generacji.
Unikanie antybiotyków, na które dany szczep wykazuje oporność, jest niezwykle istotne, gdyż stosowanie ich może skutkować niepowodzeniem terapii oraz przyczyniać się do narastania odporności bakterii. Dlatego znajomość wrażliwości tych mikroorganizmów na antybiotyki jest fundamentalna dla osiągnięcia pozytywnych efektów leczenia. Również regularne monitorowanie sytuacji epidemiologicznej w szpitalach ma ogromne znaczenie, ponieważ umożliwia skuteczniejsze zwalczanie zakażeń wywołanych przez Enterobacter cloacae.
Dlaczego Enterobacter cloacae jest odporny na wiele antybiotyków?
Enterobacter cloacae wykazuje znaczną oporność na różnorodne antybiotyki, co jest głównie efektem produkcji enzymów, takich jak beta-laktamazy AmpC. Enzymy te potrafią niszczyć antybiotyki beta-laktamowe, co znacznie obniża ich efektywność w walce z tymi bakteriami. Dodatkowo, bakterie zyskują oporność dzięki:
- mutacjom genetycznym,
- transferowi genów, które mogą pochodzić od innych mikroorganizmów.
Taki proces prowadzi do powstawania szczepów, które są szczególnie trudne w terapii. W badaniach klinicznych stwierdzono, że te mechanizmy mają istotny wpływ na wzrost liczby zakażeń szpitalnych wywołanych przez Enterobacter cloacae. Tego rodzaju sytuacje stają przed specjalistami poważne wyzwania przy wyborze najbardziej odpowiedniej terapii. Dlatego niezwykle istotne jest, aby przeprowadzać dokładne antybiogramy, które umożliwiają zidentyfikowanie skutecznych antybiotyków do leczenia tych infekcji.
Co to jest baktatomocz i jakie ma znaczenie kliniczne?

Baktatomocz odnosi się do wykrycia bakterii w moczu i może mieć różne konsekwencje kliniczne. Możemy wyróżnić dwie formy tego zjawiska:
- baktatomocz bezobjawowy – pacjent nie odczuwa żadnych dolegliwości,
- baktatomocz objawowy – mogą pojawić się nieprzyjemne symptomy takie jak ból, pieczenie w trakcie oddawania moczu oraz częste parcie na pęcherz.
To, że pacjent ma objawy, często sugeruje aktywne zakażenie układu moczowego, które wymaga szybkiej interwencji medycznej. Nieleczone zakażenia mogą prowadzić do poważnych powikłań, jak na przykład odmiedniczkowe zapalenie nerek. Według statystyk, bakteriemocz, zwłaszcza spowodowany przez takie patogeny jak Enterobacter cloacae, staje się znaczącym czynnikiem ryzyka w szpitalach.
Mimo że wiele przypadków baktatomoczu jest bezobjawowych, niezwykle istotne jest, aby regularnie przeprowadzać badania i w razie potrzeby podejmować leczenie, aby uniknąć poważnych infekcji. Do czynników sprzyjających wystąpieniu baktatomoczu należą:
- cewnikowanie,
- problemy z odpływem moczu,
- osłabiona odporność.
Analizując skład moczu oraz wykonując posiew, można ustalić przyczynę obecności bakterii i rozpocząć odpowiednie leczenie.




